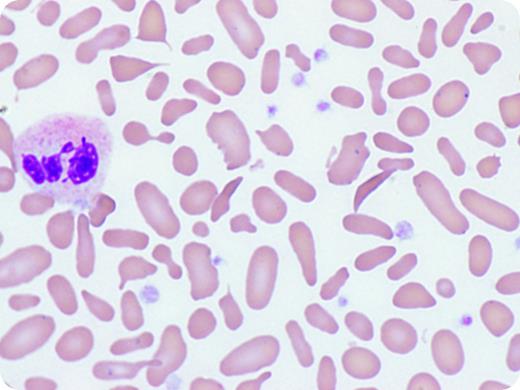
A 53-year-old asymptomatic African American man was evaluated for a lifelong history of anemia and thrombocytosis resulting from a splenectomy performed in childhood for unknown reasons. His complete blood count showed red blood cells, 5.79 × 106/μL; hemoglobin, 10.5 g/dL; mean corpuscular volume, 55.8 fL; and platelets, 878 × 109/L. Iron studies were normal. Hemoglobin electrophoresis showed hemoglobin A (56%), elevated hemoglobin A2 (3.9%), hemoglobin S (39.4%), and hemoglobin F (0.7%). These findings support β-thalassemia with hemoglobin S trait. The peripheral smear red blood cell count showed marked anisopoikilocytosis with elliptocytes (>30%), dacrocytes, sickle cells, and Howell-Jolley bodies (Wright-Giemsa stain; original magnification ×100, oil immersion). A bone marrow biopsy was performed, which revealed normal morphology and cytogenetics, ruling out a myeloproliferative disorder. The patient's father had hemoglobin S trait, but there is no other history of hemoglobinopathy. / The smear findings illustrated are highly unusual for hemoglobin S trait and β+ thalassemia, which would have mild microcytic anemia (mean corpuscular volume, 70-80 fL) with increased target cells and rare sickle cells. In this case, anisopoikilocytosis was prominent, including >30% elliptocytes. This is diagnostic of a red cell membrane defect, such as hereditary elliptocytosis. The morphology revealed the probable cause for the remote splenectomy and provides important information for family members.

A 53-year-old asymptomatic African American man was evaluated for a lifelong history of anemia and thrombocytosis resulting from a splenectomy performed in childhood for unknown reasons. His complete blood count showed red blood cells, 5.79 × 106/μL; hemoglobin, 10.5 g/dL; mean corpuscular volume, 55.8 fL; and platelets, 878 × 109/L. Iron studies were normal. Hemoglobin electrophoresis showed hemoglobin A (56%), elevated hemoglobin A2 (3.9%), hemoglobin S (39.4%), and hemoglobin F (0.7%). These findings support β-thalassemia with hemoglobin S trait. The peripheral smear red blood cell count showed marked anisopoikilocytosis with elliptocytes (>30%), dacrocytes, sickle cells, and Howell-Jolley bodies (Wright-Giemsa stain; original magnification ×100, oil immersion). A bone marrow biopsy was performed, which revealed normal morphology and cytogenetics, ruling out a myeloproliferative disorder. The patient's father had hemoglobin S trait, but there is no other history of hemoglobinopathy.
The smear findings illustrated are highly unusual for hemoglobin S trait and β+ thalassemia, which would have mild microcytic anemia (mean corpuscular volume, 70-80 fL) with increased target cells and rare sickle cells. In this case, anisopoikilocytosis was prominent, including >30% elliptocytes. This is diagnostic of a red cell membrane defect, such as hereditary elliptocytosis. The morphology revealed the probable cause for the remote splenectomy and provides important information for family members.
A 53-year-old asymptomatic African American man was evaluated for a lifelong history of anemia and thrombocytosis resulting from a splenectomy performed in childhood for unknown reasons. His complete blood count showed red blood cells, 5.79 × 106/μL; hemoglobin, 10.5 g/dL; mean corpuscular volume, 55.8 fL; and platelets, 878 × 109/L. Iron studies were normal. Hemoglobin electrophoresis showed hemoglobin A (56%), elevated hemoglobin A2 (3.9%), hemoglobin S (39.4%), and hemoglobin F (0.7%). These findings support β-thalassemia with hemoglobin S trait. The peripheral smear red blood cell count showed marked anisopoikilocytosis with elliptocytes (>30%), dacrocytes, sickle cells, and Howell-Jolley bodies (Wright-Giemsa stain; original magnification ×100, oil immersion). A bone marrow biopsy was performed, which revealed normal morphology and cytogenetics, ruling out a myeloproliferative disorder. The patient's father had hemoglobin S trait, but there is no other history of hemoglobinopathy.
The smear findings illustrated are highly unusual for hemoglobin S trait and β+ thalassemia, which would have mild microcytic anemia (mean corpuscular volume, 70-80 fL) with increased target cells and rare sickle cells. In this case, anisopoikilocytosis was prominent, including >30% elliptocytes. This is diagnostic of a red cell membrane defect, such as hereditary elliptocytosis. The morphology revealed the probable cause for the remote splenectomy and provides important information for family members.
For additional images, visit the ASH IMAGE BANK, a reference and teaching tool that is continually updated with new atlas and case study images. For more information visit http://imagebank.hematology.org.